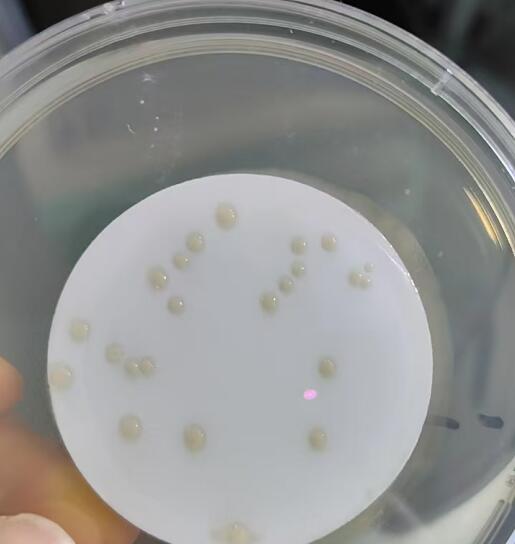

在制藥、食品、化妝品等行業(yè)中,純化水的質(zhì)量至關(guān)重要。其中,微生物限度檢驗(yàn)是評(píng)估純化水質(zhì)量的重要指標(biāo)之一。本文將詳細(xì)介紹純化水微生物限度檢驗(yàn)的操作方法。
一、檢驗(yàn)前準(zhǔn)備
設(shè)備和材料
無(wú)菌培養(yǎng)皿、移液管、試管、 微生物限度檢驗(yàn)儀等。
營(yíng)養(yǎng)瓊脂培養(yǎng)基、玫瑰紅鈉瓊脂培養(yǎng)基等。
高壓蒸汽滅菌器、恒溫培養(yǎng)箱等。
超凈工作臺(tái)或生物安全柜。
樣品采集
按照相關(guān)標(biāo)準(zhǔn)和規(guī)范,使用無(wú)菌容器采集純化水樣品。確保采樣過(guò)程中避免污染。

二、檢驗(yàn)步驟
制備培養(yǎng)基
根據(jù)需要,制備營(yíng)養(yǎng)瓊脂培養(yǎng)基和玫瑰紅鈉瓊脂培養(yǎng)基。將培養(yǎng)基成分溶解于適量蒸餾水中,加熱至完全溶解,調(diào)節(jié) pH 值,分裝至培養(yǎng)皿或試管中,經(jīng)高壓蒸汽滅菌后備用。
稀釋樣品
取適量純化水樣品,用無(wú)菌生理鹽水進(jìn)行系列稀釋。通常可制備 1:10、1:100、1:1000 等稀釋度的樣品。
接種
分別吸取不同稀釋度的樣品,注入無(wú)菌培養(yǎng)皿中。每個(gè)稀釋度接種多個(gè)培養(yǎng)皿,一般每個(gè)稀釋度接種 2~3 個(gè)培養(yǎng)皿。
對(duì)于營(yíng)養(yǎng)瓊脂培養(yǎng)基,可采用傾注法接種,即將冷卻至 45℃左右的培養(yǎng)基傾注于培養(yǎng)皿中,與樣品充分混合。對(duì)于玫瑰紅鈉瓊脂培養(yǎng)基,可采用涂布法接種,即用無(wú)菌玻璃涂布棒將樣品均勻涂布于培養(yǎng)基表面。
培養(yǎng)
將接種后的培養(yǎng)皿倒置放入恒溫培養(yǎng)箱中培養(yǎng)。營(yíng)養(yǎng)瓊脂培養(yǎng)基在 30~35℃下培養(yǎng) 3~5 天,玫瑰紅鈉瓊脂培養(yǎng)基在 23~28℃下培養(yǎng) 5~7 天。
計(jì)數(shù)
培養(yǎng)結(jié)束后,觀察培養(yǎng)皿中的菌落生長(zhǎng)情況。統(tǒng)計(jì)每個(gè)培養(yǎng)皿中的菌落數(shù),并根據(jù)稀釋倍數(shù)計(jì)算出樣品中的微生物含量。
三、結(jié)果判定
按照相關(guān)標(biāo)準(zhǔn)和規(guī)范,確定純化水的微生物限度標(biāo)準(zhǔn)。
將檢驗(yàn)結(jié)果與標(biāo)準(zhǔn)進(jìn)行比較,判斷純化水是否符合質(zhì)量要求。
四、注意事項(xiàng)
檢驗(yàn)過(guò)程應(yīng)在無(wú)菌條件下進(jìn)行,嚴(yán)格遵守?zé)o菌操作規(guī)范。
培養(yǎng)基的制備和滅菌應(yīng)嚴(yán)格按照操作規(guī)程進(jìn)行,確保培養(yǎng)基的質(zhì)量。
樣品采集和稀釋過(guò)程中,應(yīng)避免污染,確保樣品的代表性。
培養(yǎng)箱的溫度和時(shí)間應(yīng)嚴(yán)格控制,以保證檢驗(yàn)結(jié)果的準(zhǔn)確性。
檢驗(yàn)人員應(yīng)經(jīng)過(guò)專業(yè)培訓(xùn),熟悉檢驗(yàn)方法和操作規(guī)程。
純化水微生物限度檢驗(yàn)是一項(xiàng)重要的質(zhì)量控制工作,通過(guò)嚴(yán)格的操作方法和規(guī)范的檢驗(yàn)流程,可以確保純化水的質(zhì)量安全,為相關(guān)行業(yè)的生產(chǎn)和發(fā)展提供保障。







 客服1
客服1